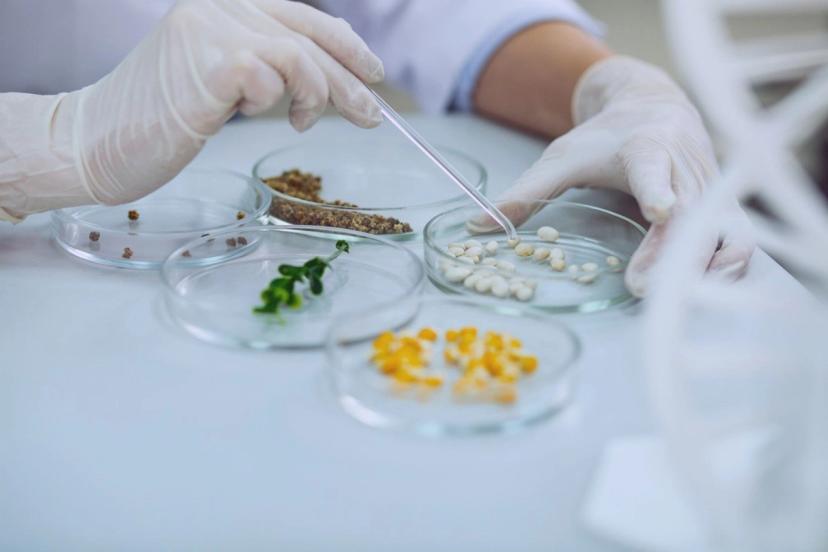

Ensuring food quality, safety, and authenticity
Explore the cutting-edge technologies and methods driving advancements in food quality, safety, and authenticity, from streamlined quality control monitoring to automated cryogen-free analysis systems
19 Feb 2024

In today's rapidly evolving food landscape, ensuring the integrity of our food supply chain has become more critical than ever. From concerns over foodborne illnesses to the rise of counterfeit products, consumers are increasingly demanding more transparency in the foods they consume. When consumers can rely on the safety and quality of the food they purchase, they are more likely to make informed choices and support businesses that prioritize safety and quality.
Unsafe or poor-quality food can lead to a range of illnesses, from mild cases of food poisoning to more severe and sometimes life-threatening conditions. This can also result in companies discarding entire batches of food, which can harm their brand reputation. Ensuring food safety and meeting relevant regulations, safeguards consumers from these risks, promoting overall well-being, and reducing the burden on our healthcare systems. Food safety testing involves analyzing samples for microbiological, physical, and chemical components. Various analytical methods are used to detect contamination, residues, pesticides, dioxins, PFAS, and mycotoxins. Additionally, it includes assessing shelf-life and analyzing food packaging materials for safety. Authenticity testing ensures transparency in the food supply chain by confirming the accuracy of food products and their ingredients, and with the emergence of more meat alternative and vegan products, these too undergo rigorous testing to meet safety standards.
Read on to explore the latest technologies and methodologies that are driving advancements in food quality, safety, and authenticity. By exploring topics such as effective quality control monitoring and automated cryogen-free analysis, we aim to shed light on the innovative solutions that are reshaping the way we approach food assurance.
1. Achieve same-day strain typing results
In this video, find out how the Bruker IR Biotyper® system is designed to enable microbial strain typing for rapid source tracking and quality control monitoring.
2. Cryogenic homogenization in food sample preparation
Discover Retsch's GRINDOMIX GM 200 knife mill, developed for homogenizing food samples with varied properties such as high water, oil, sugar, or fat content. This mill provides reproducible preparation of samples, ensuring minimum standard deviation of analysis results.
3. Power of NIR: Benefits, investment strategies, and ROI
Discover how BUCHI’s NIR solutions are rapid, versatile, and non-destructive, and why eco-friendly analysis is preferred over traditional wet chemistry. Plus, learn how to wisely invest in or upgrade NIR equipment, considering the high initial cost and the necessity of conducting ROI analysis.
4. Fully automated cryogen-free analysis of ethylene oxide and 2-chloroethanol
Learn about an efficient extraction technique for the analysis of ethylene oxide and 2-chloroethanol in foods using headspace-trap, multi-step enrichment and GC-MS. Plus, explore how this approach has improved sensitivity to enhance food safety measures.
5. Navigating microbiological risks in global food networks
Strong microbiological defences, including advanced technologies like PCR DNA fingerprinting, are crucial for accurate detection. Discover how the Stomacher® lab blenders play a vital role in sample preparation for these essential techniques, supported by ongoing development from Seward Limited.
6. Analyzing moisture and ash for food quality assurance
Moisture and ash content are key indicators of food quality, influencing factors such as nutritional value, shelf-life, appearance, texture, and taste. Learn how to efficiently and accurately analyze these parameters using the Techcomp Lab Products by Precisa series 340 prepASH® thermogravimetric analyzer.
7. Top considerations for the food testing laboratory
View this video for comprehensive insights into food contamination, pesticides, food fraud, and the essential technologies required for ensuring food safety. Additionally, explore key considerations that testing laboratories must prioritize to guarantee food quality, safety, and authenticity.